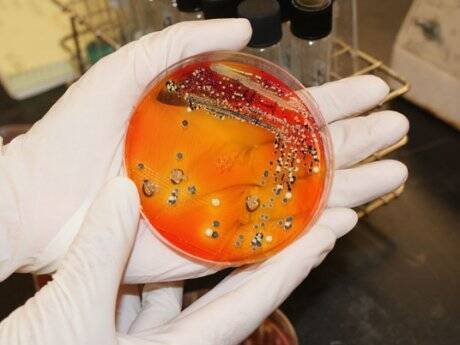

Din ţânţar, armăsar! Carne de pui infestată cu salmonella: România, pe lista țărilor ”reclamate” în ultimele 40 de zile
Germania a notificat prin sistemul european rapid de alertă descoperirea unor cantităţi de carne de pui infestată de salmonella, exportată de România – deşi unele voci vorbesc despre o nouă criză a cărnii, lucrurile nu stau deloc aşa.
Prin sistemul european rapid de informare referitor la alimente şi furaje sînt sesizate curent problemele care sînt descoperite – practic nu există vreo ţară membră UE sau ţară non-U care să nu se regăsească în baza de date a sistemului în dreptul unei notificări referitoare la posibile riscuri asupra sănătăţii şi siguranţei alimentare. Nu notificările în sine indică existenţa unor probleme majore în sistem.
În cazul notificării germane (2013.1068) atât cantitatea cât şi genul de problemă ridicată indică o problemă cât se poate de comună.
O cantitatea de 3,4 tone este infimă la nivelul fluxurilor obişnuite – trebuie să ţinem cont că un container are 25 de tone – ceea ce ne face să vorbim despre o parte dintr-un transport.
Cazurile de carne de pui infestate cu salmonela apar în mod curent, fiind unele dintre problemele cele mai recurente. Potrivit bazei de date a sistemului european de alertă rapidă doar în ultimele 40 de zile au fost înregistrate 20 de notificări de acest fel.
Printre ţările menţionate în aceste notificări apar pe lângă România – Ungaria, Cehia, Polonia, Franţa şi Brazilia. Dintre ele doar ţara noastră şi Franţa apar doar o singură dată.
Este un gen de problemă care la nivel european este sesizat o data la două zile – este greu să te gândeşti că ar putea deveni subiect de ştire, darămite să anunţi din acesta o criză!









